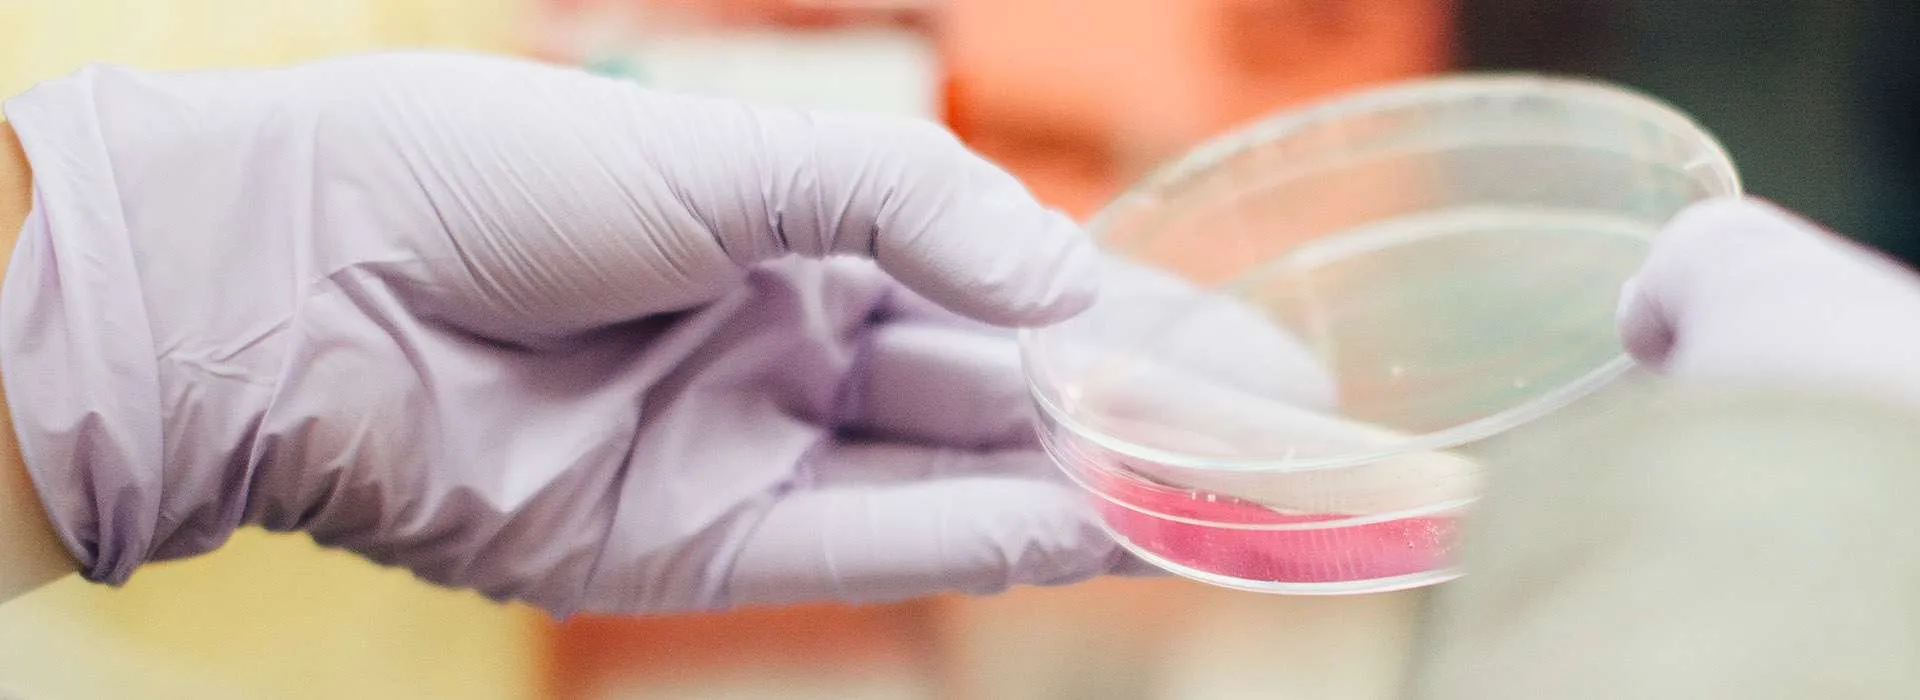
Dietetic Placement Portfolios & Profiles

Placement Portfolios
Please note, some of our documents are not currently fully accessible. Please contact us through dietetics@rgu.ac.uk if you need further information or help.
Student Placement A Portfolio
Student Placement B Portfolio
Student Placement C Portfolio
Provider Profiles
NHS Health Board websites are useful resources of information about the Health Board and its local population.
The SHOW Website provides links to each of Scotland's NHS Health Boards.
- NHS Ayrshire - Arran (PDF 136KB)
- NHS Borders (PDF 119KB)
- NHS Dumfries & Galloway (PDF 164KB)
- NHS Fife (PDF 81KB)
- NHS Forth Valley (PDF 305KB)
- NHS GG&C - Acute Adult Division (PDF 112KB)
- NHS GG&C - Community (PDF 147KB)
- NHS GG&C - Mental Health (PDF 143KB)
- NHS Grampian - Moray (PDF 102KB)
- NHS Grampian (PDF 130KB)
- NHS Highland (PDF 101KB)
- NHS Lanarkshire (PDF 105KB)
- NHS Lothian (PDF 53KB)
- NHS Orkney (PDF 94KB)
- NHS Shetland (PDF 101KB)
- NHS Tayside (PDF 58KB)
- The Golden Jubilee National Hospital (PDF 109KB)
- The State Hospital (PDF 58KB)
- Western Isles (PDF 55KB)